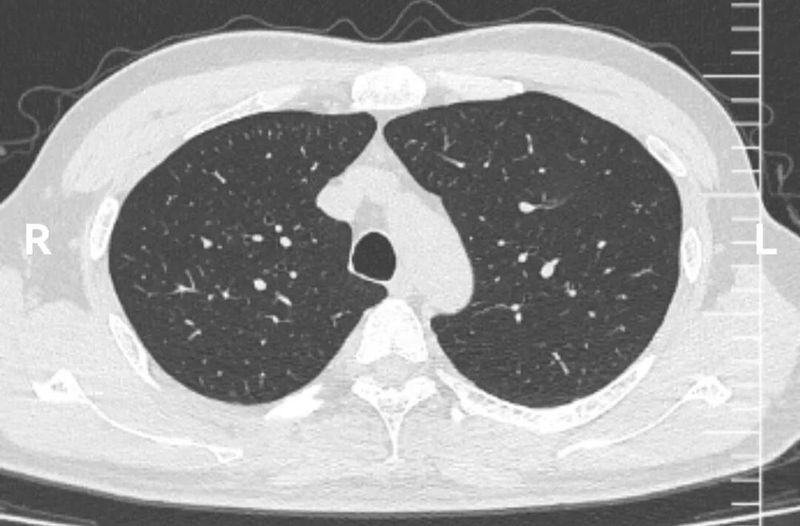
图片
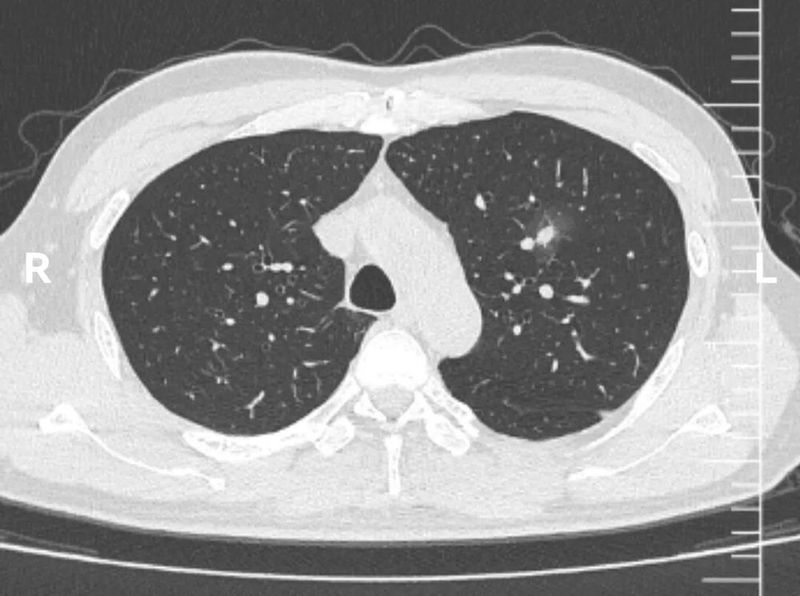
图片
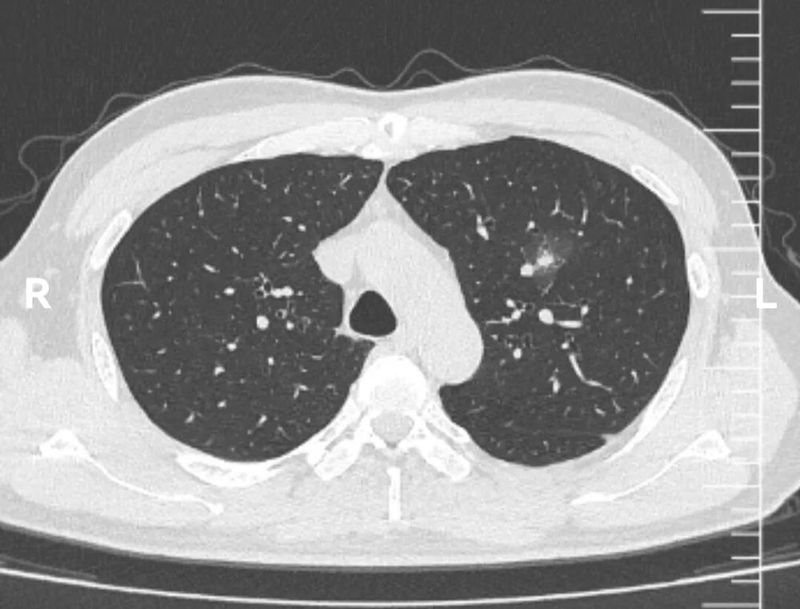
图片
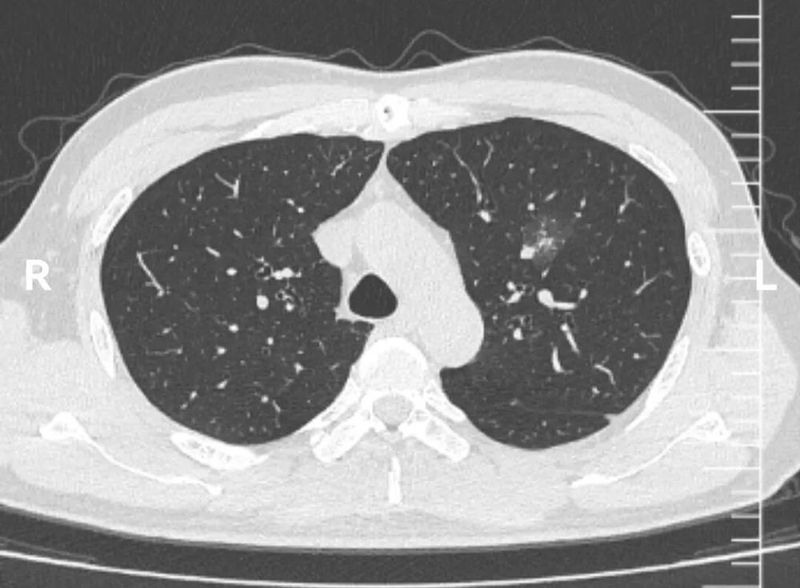
图片
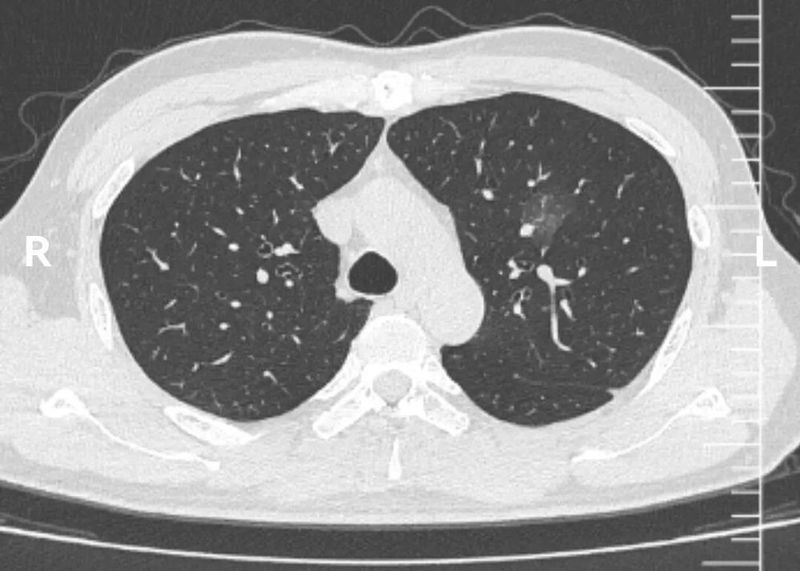
图片
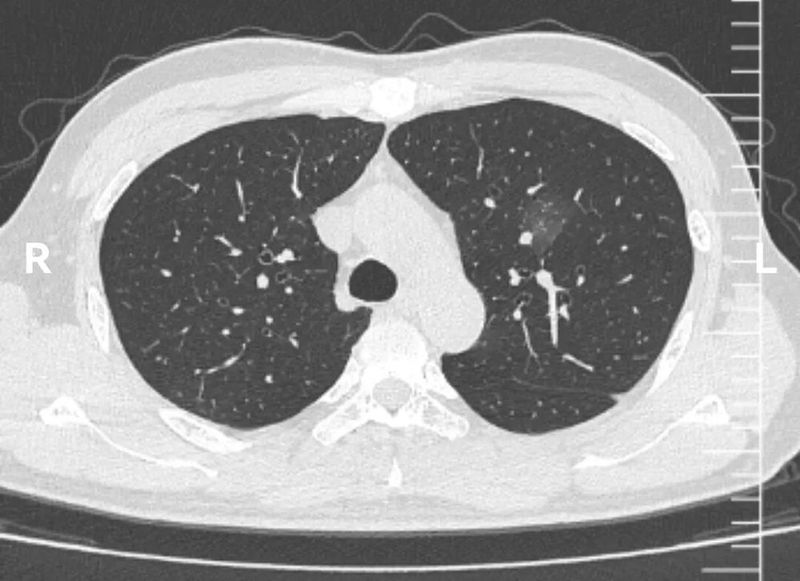
图片

以"荷包蛋征"为表现的混杂性磨玻璃结节,往往被认为高风险。甚至被认为是肺癌的典型征象。但是实际上这种混杂磨玻璃结节也有炎症可能。那么鉴别诊断的关键在哪里?
病史:
51岁男性,2025年11月体检发现左肺上叶混杂磨玻璃结节2cm。回顾20263年12月CT,该位置未见该结节。动图见下。根据肺结节诊断规律,由于混杂磨玻璃结节如果为肿瘤性,应生长缓慢,如果2年内新出的混杂磨玻璃结节,则极大概率为炎症。从这位患者的病史上,即可基本排除恶性。那么再看一下这个结节的CT形态。
CT图像

这个左上肺混杂磨玻璃结节CT图像非常有特点,首先,磨玻璃成分为主,而且磨玻璃成分边界模糊不清。这本身就是炎症的典型表现。其次,实性成分的形态边界比较清楚,没有分叶、血管异常等形态。
这些CT征象联合一年新出现的病史,已经可以肯定该结节为炎症性,建议患者口服抗生素治疗2周,再一个月复查CT。
1个月后复查CT,该结节如愿明显吸收。

总结
再次强调下,1-2年内新出的,磨玻璃边界不清的「荷包蛋」型混杂磨玻璃结节,可判断为炎症。可给予抗炎后1个月复查。
